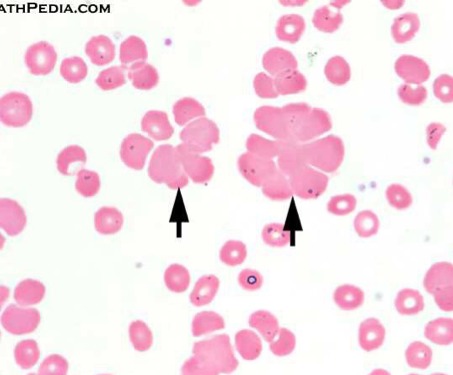

Sign up for FlowVella
Sign up with FacebookAlready have an account? Sign in now
By registering you are agreeing to our
Terms of Service
Loading Flow

Agglutination
These cells have an appearance of clusters, a feathered edge, and an irregular rbc.
Common diseases/conditions are paraprotein, cold agglutinin disease, and hemolytic anemia